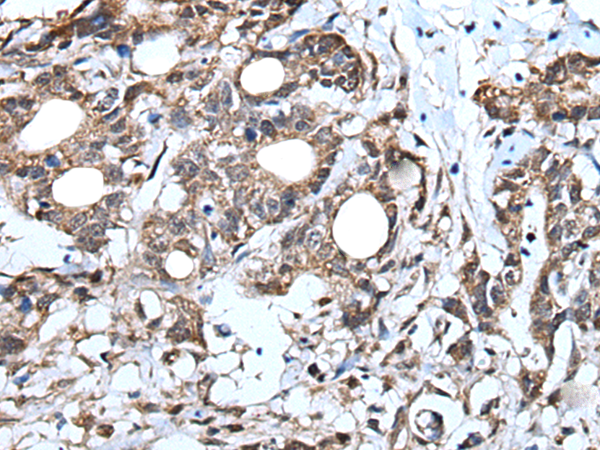
一抗

別 名: MUM1; LSIRF; SHEP8; NF-EM5
技術(shù)規(guī)格
|
Background: |
The protein encoded by this gene belongs to the IRF (interferon regulatory factor) family of transcription factors, characterized by an unique tryptophan pentad repeat DNA-binding domain. The IRFs are important in the regulation of interferons in response to infection by virus, and in the regulation of interferon-inducible genes. This family member is lymphocyte specific and negatively regulates Toll-like-receptor (TLR) signaling that is central to the activation of innate and adaptive immune systems. A chromosomal translocation involving this gene and the IgH locus, t(6;14)(p25;q32), may be a cause of multiple myeloma. Alternatively spliced transcript variants have been found for this gene. |
|
Applications: |
ELISA, IHC |
|
Name of antibody: |
IRF4 |
|
Immunogen: |
Fusion protein of human IRF4 |
|
Full name: |
interferon regulatory factor 4 |
|
Synonyms: |
MUM1; LSIRF; SHEP8; NF-EM5 |
|
SwissProt: |
Q15306 |
|
ELISA Recommended dilution: |
2000-5000 |
|
IHC positive control: |
Human brain and human lung cancer |
|
IHC Recommend dilution: |
30-150 |

 購物車
購物車 幫助
幫助
 021-54845833/15800441009
021-54845833/15800441009